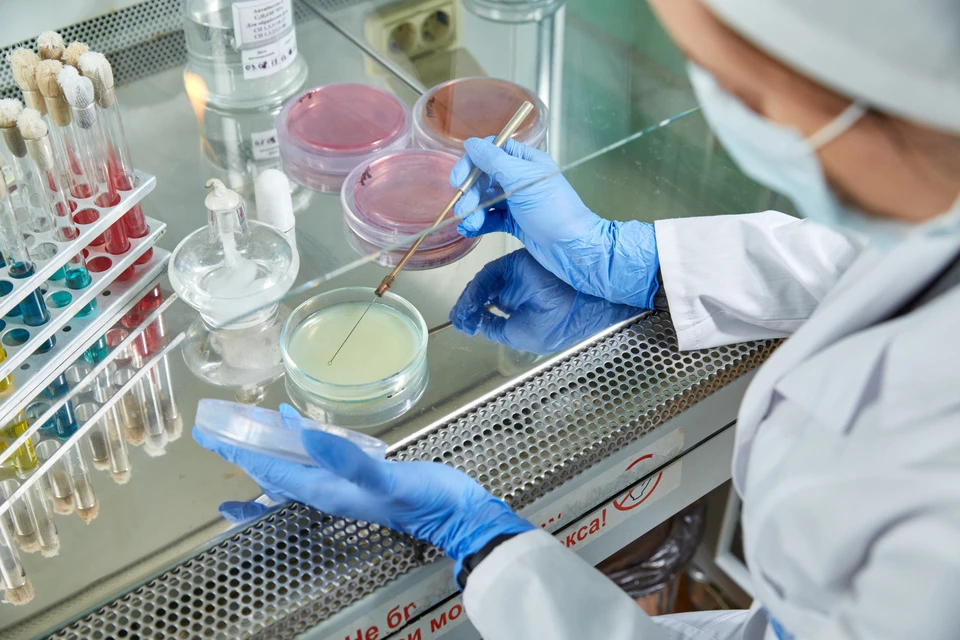

Тверь
ФотоВидеоСпецоперацияПолитикаОбществоЭкономикаВ миреЗвездыЗдоровьеСоцподдержкаНаукаСпортКолумнистыПроисшествияНациональные проекты РоссииВыбор экспертовДокторФинансыОткрываем мирЯ знаюСемьяЖенские секретыПутеводительКнижная полкаПрогнозы на спортПромокодыСериалыСпецпроектыДефицит железаТуризмПресс-центрНедвижимостьТелевизорКоллекцииКонкурсыРабота у насГид потребителяВсе о КПРадио КПРекламаТестыНовое на сайте
Еще
Тверь
ФотоВидеоСпецоперацияПолитикаОбществоЭкономикаВ миреЗвездыЗдоровьеСоцподдержкаНаукаСпортКолумнистыПроисшествияНациональные проекты РоссииВыбор экспертовДокторФинансыОткрываем мирЯ знаюСемьяЖенские секретыПутеводительКнижная полкаПрогнозы на спортПромокодыСериалыСпецпроектыДефицит железаТуризмПресс-центрНедвижимостьТелевизорКоллекцииКонкурсыРабота у насГид потребителяВсе о КПРадио КПРекламаТестыНовое на сайте
Еще
Сегодня:
Еще
Специалисты лаборатории подтвердили, что найденные в рыбе возбудители болезней не угрожают здоровью человека. Фото: "ВНИИЗЖ".
Специалисты Тверской испытательной лаборатории ФГБУ «ВНИИЗЖ» 23 марта 2026 года завершили исследования образцов речной рыбы. В биоматериале от окуня и красноперки эксперты обнаружили возбудителей диплостомоза и тетракотилеза.
Пробы поступили от регионального Россельхознадзора по Тверской и Ярославской областям. Исследования показали, что 60% образцов поражено диплостомозом, а 20% — тетракотилезом.
Специалисты успокаивают: для здоровья человека эти паразиты не опасны, но они вредят самим рыбам, значительно снижая их продуктивность. Сведения о результатах экспертизы уже внесены в федеральные системы «Веста» и раннего оповещения для принятия необходимых мер.